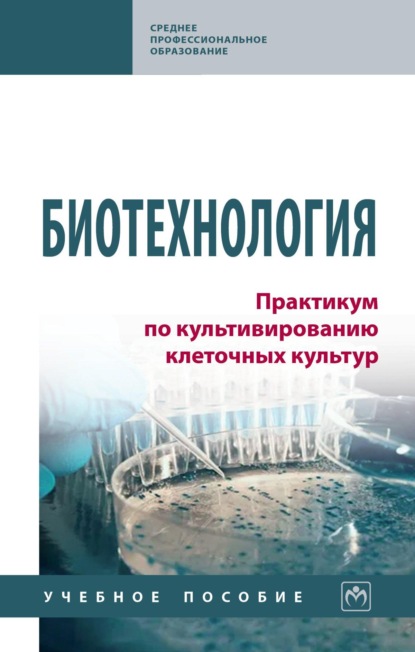
Скачать книгу Биотехнология. Практикум по культивированию клеточных культур

Биотехнология. Практикум по культивированию клеточных культур
Полная версия
В учебном пособии представлены основные методические подходы к работе с культурами клеток: ведение клеточных культур, их пассирование, подсчет клеток в единице объема, приготовление растворов антибиотиков, диспергирующих растворов и питательных сред для работы с клеточными культурами, контаминация клеточных культур и методы ее обнаружения, криоконсервация клеток, техника безопасности при работе в боксовом помещении с клеточными культурами, биобезопасность при работе с клеточными культурами. Соответствует требованиям федеральных государственных образовательных стандартов среднего профессионального образования последнего поколения. Предназначено для специалистов и студентов учреждений среднего профессионального и высшего образования, квалифицирующихся в области биотехнологии и вирусологии для решения задач широкого диапазона.
- О книге